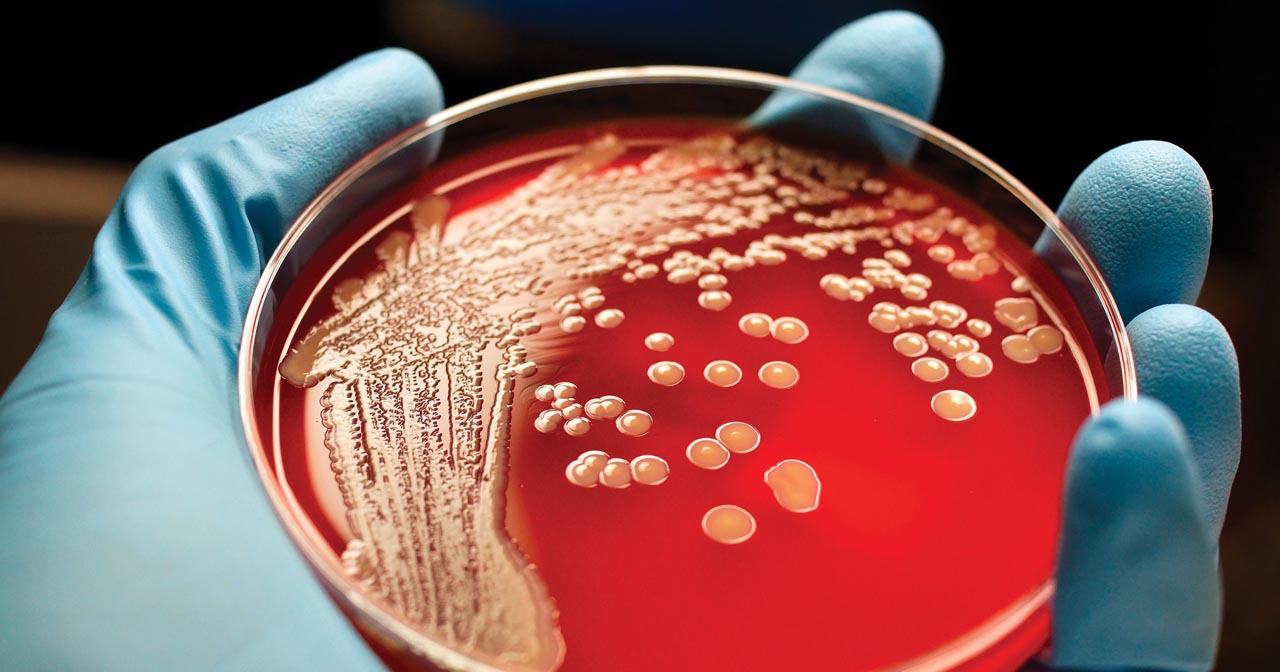

Bakteri, tek hücreli mikroorganizma grubudur. Tipik olarak birkaç mikrometre uzunluğunda olan bakterilerin çeşitli şekilleri vardır, kimi küresel, kimi spiral şekilli, kimi çubuksu, kimi virgül şeklinde olabilir. Yeryüzündeki her ortamda bakteriler mevcuttur. Toprakta, deniz suyunda, okyanusun derinliklerinde, yer kabuğunda, deride, hayvanların bağırsaklarında, asitli sıcak su kaynaklarında, radyoaktif atıklarda yaşayabilen tipleri vardır. Tipik olarak bir gram toprakta bulunan bakteri hücrelerinin sayısı -yaklaşık- 40 milyon, bir mililitre tatlı suda ise -yaklaşık- 1 milyondur; toplu olarak dünyada beş nonilyon (5×1030) bakteri bulunmaktadır, bunlar dünyadan biyokütlenin çoğunu oluşturur. Bakteriler gıdaların geri dönüşümü için hayati bir öneme sahiptirler ve gıda döngülerindeki çoğu önemli adım, atmosferden azot fiksasyonu gibi, bakterilere bağlıdır. Ancak bu bakterilerin çoğu henüz tanımlanmamıştır ve bakteri şubelerinin sadece yaklaşık yarısı laboratuvarda kültürlenebilen türlere sahiptir. Bakterilerin araştırıldığı bilim bakteriyolojidir, bu mikrobiyolojinin bir dalıdır.
İnsan Vücudundaki Bakteri Sayısı
Bilim insanları yıllar boyunca vücudumuzun kendi hücrelerimizin 10 katı kadar bakteri barındırdığını tahmin ediyordu. Ancak son yıllarda yapılan araştırmalar farklı bir sonuç verdi. İsrail ve Kanadalı araştırma ekibinin 2016’da yaptığı yeni hesaplara göre, vücudumuzda yaklaşık olarak kendi hücrelerimiz kadar bakteri bulunuyor. Özellikle deride ve sindirim yolu içinde (çoğu kalın bağırsakta) çok sayıda bakteri bulunuyor. EMAR taramalarında elde edilen bilgilere dayanarak ortalama bir insanın bağırsak hacmi hesaplanıyor. Bir gram dışkıda 90 milyar bakteri bulunduğundan yola çıkarak vücuttaki toplam bakteri sayısının 38 trilyon civarında olduğu tespit ediliyor. Ortalama bir vücuttaki toplam insan hücresi sayısı ise 30-40 trilyon arasında olduğu tahmin ediliyor. Araştırmalara göre her 1 hücreye 1 bakteri hücresi düşüyor ancak bunlar bir arada o kadar küçük hücreler ki insan vücudunun yüzde 1’ine tekabül ediyor. Yani 75 kilo bir insanın vücudunda 200 gram bakteri mevcut.
Bakteriler, morfoloji olarak adlandırılan, şekil ve boyutları bakımından büyük bir çeşitlilik gösterir. Bakteriyel hücreler ökaryotik bir hücrenin yaklaşık onda biri boyundadır, tipik olarak 0,5-5,0 mikrometre uzunluktadırlar. Ancak, birkaç tür, örneğin Thiomargarita namibiensis ve Epulopiscium fishelsoni yarı milimetre boyunda olabilir ve çıplak gözle görülebilir. En küçük bakteriler arasında Mikoplazma cinsinin üyeleri bulunur, 0,3 mikrometre olan bu bakteriler en büyük virüsler kadar küçüktür. Bazı bakteriler daha da küçük olabilirler ama bu ultramikrobakteriler henüz iyi tanımlanmamıştır.
Bakterilerin çok büyük çoğunluğu bağışıklık sisteminin koruyucu etkisiyle zararsız kılınmış durumdadırlar. Ayrıca bir kısmı da yararlı (probiyotik) olsalar da, bazıları patojen bakterilerdir ve enfeksiyöz hastalıklara neden olurlar; kolera, frengi, şarbon, cüzzam ve veba bu cins hastalıklara dahildir. En yaygın ölümcül bakteriyel hastalıklar solunum yolu enfeksiyonlarıdır, bunlardan verem tek başına yılda iki milyon kişi öldürür, bunların çoğu Sahra Altı Afrika‘da bulunur. Kalkınmış ülkelerde bakteriyel enfeksiyonların tedavisinde ve çeşitli hayvancılık faaliyetlerinde antibiyotikler kullanılır, bundan dolayı antibiyotik direnci yaygınlaşmaktadır. Endüstride bakteriler, atık su arıtması, peynir ve yoğurt üretimi, biyoteknoloji, antibiyotik ve diğer kimyasalların imalatında önemli rol oynarlar.